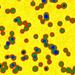

Nanostructured Materials and Interfaces
Investigating the relation between nanostructure and functional properties of materials. Our research focus is on material structures, surfaces/interfaces, and surface interactions at the nanoscale. Our research interests include phase change materials, nanoclusters/nanoparticles, nanoresonators, surface forces, friction, and adhesion. Experimental facilities include scanning probe, scanning electron, and Transmission electron microscopy. Applications of our research are connected with hydrogen storage, novel NEMS devices and phase change memories.